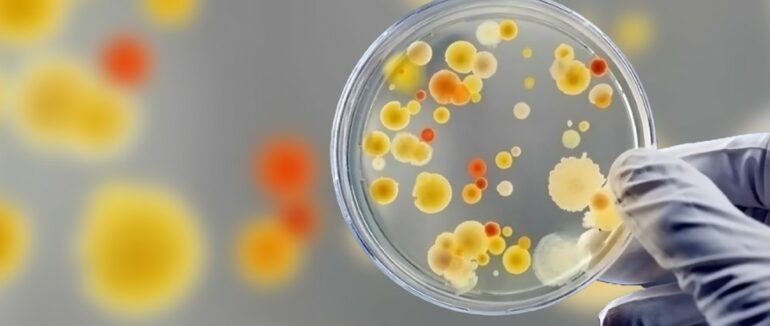
Стафілокок на Закарпатті: майже у 70 працівників їдалень виявили бактерію

У 66 працівників харчоблоків закладів освіти на Закарпатті виявили золотистий стафілокок
Про це повідомляє Суспільне з посиланням на Закарпатський обласний центр контролю та профілактики хвороб. Це 7,1 % від загальної кількості протестованих. Перевірки у закладах освіти стартували 11 жовтня.
Станом на 26 листопада перевірки представники центру контролю та профілактики хвороб провели у 335 навчальних закладах на Закарпатті. Обстежили 193 заклади дошкільної освіти, 134 заклади загальної середньої освіти та 8 інтернатних закладів.
Загалом обстежили 924 працівників харчоблоків: 498 працівників у закладах дошкільної освіти, 380 — у закладах середньої освіти та 46 — в інтернатах. Стафілокок виявили у 66 працівників харчоблоків. Результати ще 4 зразків, відібраних серед обстежених працівників харчоблоків, очікують.
На сторінці Закарпатського обласного центру контролю та профілактики хвороб повідомили: найбільший відсоток носіїв золотистого стафілокока виявили у закладах освіти Мукачівщини, Свалявщини та Виноградівщини. Не виявили — на Рахівщині, Міжгірщині та Берегівщині.
"Про всі виявлені відхилення від норм проінформували обласні та територіальні підрозділи з питань освіти та охорони здоров’я райдержадміністрацій та виконкомів рад територіальних громад та територіальні управління, а також управління і відділи Головного управління Держпродспоживслужби в Закарпатській області для відповідного реагування в межах повноважень", — йдеться у повідомленні.
Що відомо
Станом на 29 жовтня на Закарпатті у 47 працівників їдалень виявили стафілокок.
Що таке золотистий стафілокок
- На сайті Національної академії медичних наук України пояснюють, що це бактерія кулястої форми, живе в повітрі й на поверхнях предметів. Золотистий стафілокок є патогенним мікроорганізмом, тобто такий, що порушувати життєдіяльність клітин організму і руйнує його тканини. Тобто, потрапляючи на шкіру, в ніс або рот, або у внутрішні органи людини, він викликає низку захворювань. Бактерія всередині організму атакує органи викликає інтоксикацію, а якщо бактерія потрапляє у відкриту рану, можуть розвиватися гнійники, а бактерія з кров'ю розноситься організмом.
- Золотистий стафілокок одна з бактерій, які відносять до антибіотикорезистентних. Тобто штами золотистого стафілокока стійкі до лікування антибіотиками. Золотистий стафілокок потрапив до переліку ВООЗ найбільш небезпечних для людини бактерії саме через антибіотикорезистентність. Також у жовтні минулого року у ВООЗ повідомляли, що золотистий стафілокок стійкий до антибіотика метициліну, а люди, які є носіями штаму золотистого стафілокока стійкого до метициліну мають на 64% більше шансів померти, ніж ті у кого його немає.